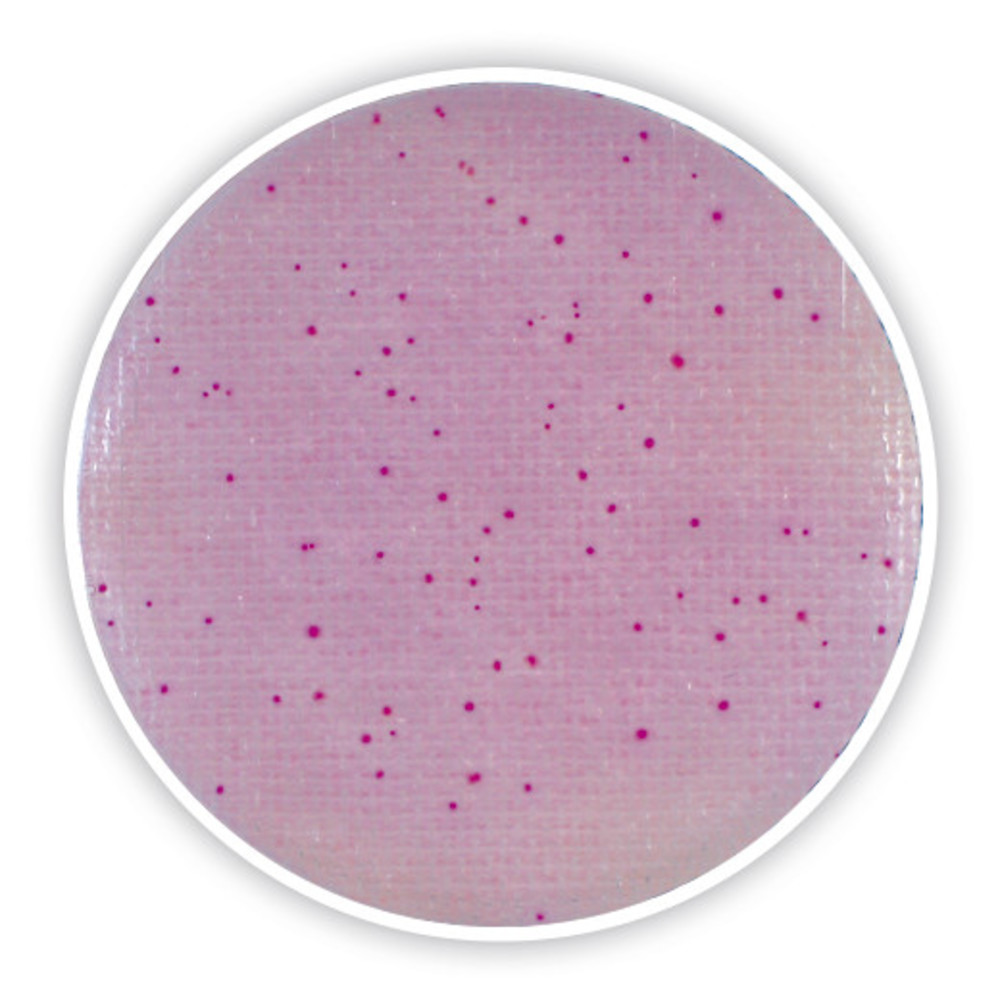
4828.1, Shimadzu
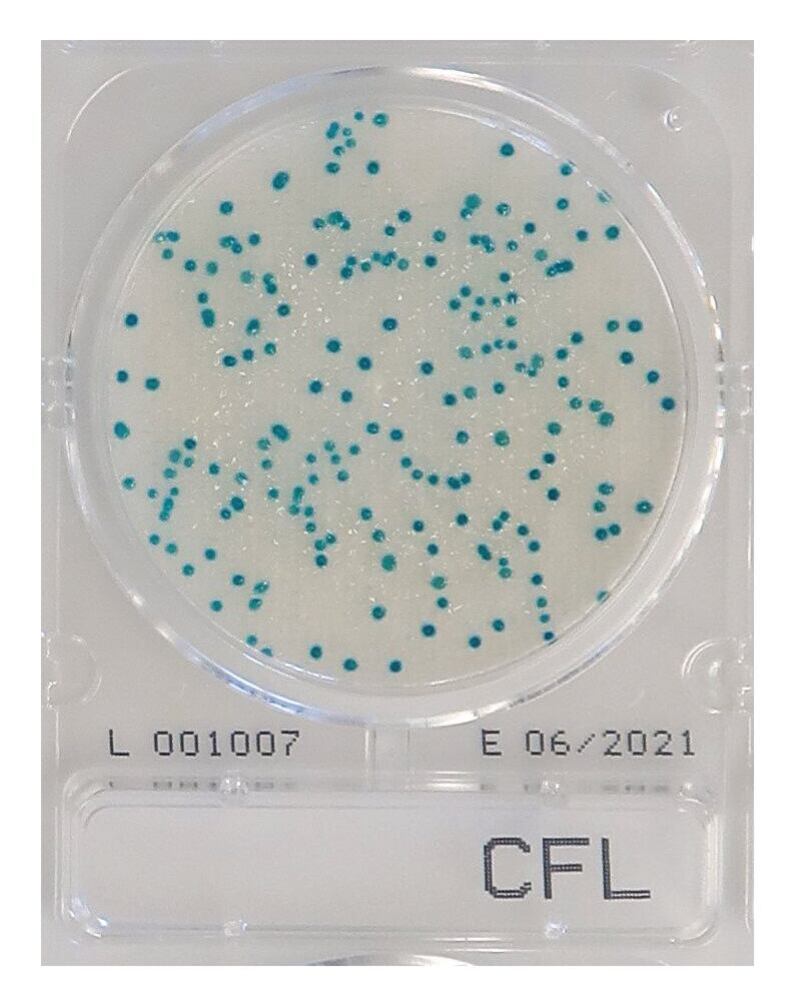
3LA9.1, Shimadzu

Products Found:
131
Showing Results For: Ready-Made Media
Ready-Made Media
FILTERS
Filters
Clear All
Mossel EE Broth, 1 l, septum bottle, 10 x 100 ml
MF Part:
37E1.2
MOQ:
1 -
£ 86.99
Get Quote
more details